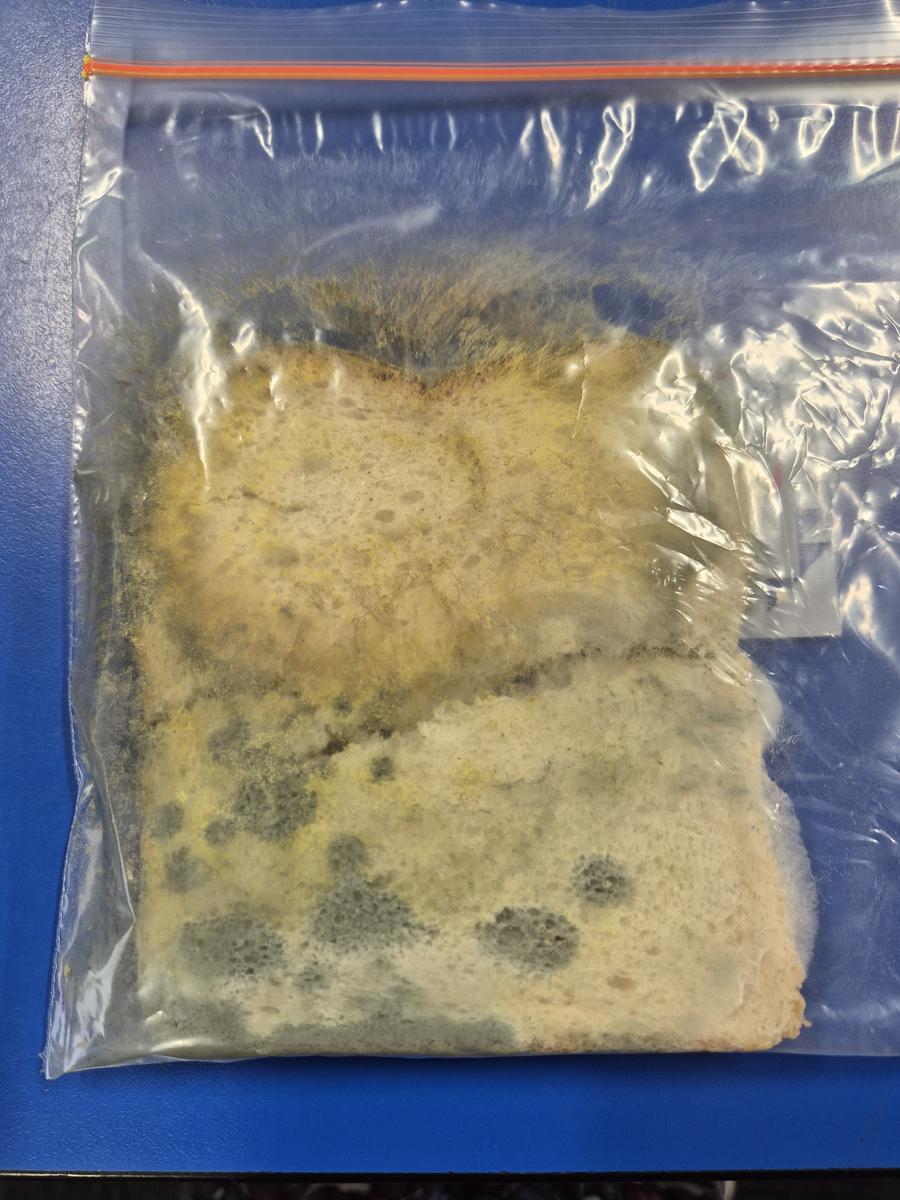
Gallery Image

Grade 5 & 6

📚 English- The Apprentice Witnesser 📚
In The Apprentice Witnesser, Basti Scull trains under the village’s Witnesser of Miracles in a world where most men have vanished after a mysterious illness. When she and her mentor, Lodyma, are called to a distant monastery, they uncover secrets that challenge everything they believe. This moving story blends mystery, courage, and hope while exploring themes of sustainability, resilience and belonging.
Look at what we've been working on in classroom!
Look at these AI Character representations
My favorite part was when Basti, Ravine and River were getting chased down by the men in the hills. The actions were well described and developed. You could picture it clearly in your mind, the pressure and desperation that Basti felt running and tripping over obstacles. - Designa
Overall it was a fantastic book, even though the book started out really bad and boring, but built up half way through. I think a lot of surprises popped out, and this kept all 24 of us entertained. Kudos to Jackie French, she did a phenomenal job at keeping the book interesting and pulling the reader in. The characters were great, particularly the pop up of Raveena. She gave us all a big plot twist, we all hated her at first, her ruthless attitude, and her selfless reputation, but then she saved Basti, and taught her the ways of a bush girl. She was involved in fleeing the traumatic scene of the men, helping Basti find the way back and taking care of River. - Flynn
Student Reviews:
🌲 Biology 🌲
During Term 4 students investigated biological science and students developed an understanding of life by exploring the needs, structures, behaviours, and relationships of living things. Students explored how living things have structural features and adaptations that help them to survive in their environment. They investigated how the form of living things enable them to function in their environments, and understand that plants and animals have internal and external structures that function to support survival, growth, behaviour and reproduction. Students also explored bacteria and the physical conditions that affect its survival, most notably with our 'Bread in the Ziplock Bag' experiment.
I wiped my bread on the toilet seat. Before, the bread looked fresh and fluffy. We left the bread in a dark spot in the room for three weeks. After that, we took out our bread. It had got really moldy!- Elvina. D
We found out just how much bacteria is on everyday items, that different bacteria lead to different colour mold (eg. Fireman pole = yellow and green fuzzy mold) and that certain surfaces have different levels of bacteria thriving on them. - Zali F
Everything has bacteria and they can look different. Some bacteria can be good for you and some can be harmful. - Penny B
We learnt what bacteria is and that it is on all surfaces. We learnt about the conditions for it to grow. - Thatcher FR
Maths
Students investigated many interesting and engaging topics in Maths during Term 4. They explored powers of ten and used multiplication and division to find unknown quantities. They used their powers of ten learning to calculate percentages e.g. 10 % off sales. Students learnt about percentages and made the connection of their fraction and decimal equivalents. Students explored the sequence of number patterns using the four operations, identifying patterns and continuing them. Students investigated cartesian planes, learning to use coordinates to plot on an X and Y axis.
My favourite Maths task was when we did KFC discount Maths. We got to choose an item and discount it by 10%, 20%, 25% or 50%. I could expand my discount skill and see how the change of discounts can actually change the prices. Mrs O taught us many different ways to figure out ways to divide the percentage into the number. - Geneva M
I enjoyed BIDMAS because I worked out how to solve the problems properly. I liked learning about factor trees because they gave my brain a real challenge!- Imogen A
I enjoyed the Fibonacci sequence because it was interesting and it was something different. I found it interesting that we can see the Fibonacci sequence in real life examples- Chloe W
🍡FEAST Program! 🍡
FEAST (Food Education and Sustainability Training)10-week curriculum-aligned education program for primary and high schools, which explores the issue of food waste and its environmental impact, positive food choices and easy classroom cooking.
Like any good FEAST, this program is fun, engaging and filled with good food!
Our Grade 5/6 students engaged in this program across Term 4, learning lots about positive food choices, healthy cooking and was thoroughly enjoyed by all. Students learnt about food preparation and opened the door to many budding chefs across the Grade 5/6 cohort.
I enjoyed FEAST it was fun, it was a great thing for all students to do, the most important thing was everyone was learning and having fun.- Semmie L
We dipped the skewers in the yoghurt and it was delicious. - Raymond R
I enjoyed cutting the fruits and vegetables up, it was a bit tricky! -Amelie W
I really liked how we got to cut it and sort out, and then actually put the fruit onto the skewers. It was awesome! - Hannah S
🤖 Grade 6 Robotics Day 🤖
Grade 6 students visited the Bendigo Tech School for an exciting, hands-on technology experience. During the excursion, students explored the world of robotics, coding, and visual effects through fun, interactive workshops. They learnt how to program robots, experiment with simple coding challenges, and immerse themselves in virtual backgrounds that encourage creativity and problem-solving.
On the 1st and 2nd of December, the grade 6's went to Bendigo Tech School for a day of learning about Robotics. Mr Palmer's and Mrs O'Connor's Grade 6s went on Monday. Then the following day, Tuesday, Mrs Chamings, Mr Gilmore's and Miss Aburrow's Grade 6s went.
At the Bendigo Tech School, we saw so many cool things like a Robot dog. We learnt how to program an Irobot and a Codey Rocky (robots that you program to go forwards and backwards, smile, and emote). We also learnt how important it is to describe things with a deal by making our partner re-build the Lego that we made. One of the other things we did was green screening, where we filmed ourselves getting interviewed about high school. Then we edited the video and added backgrounds. We had so much fun and we thank all 5-6 teachers for organising this amazing 2 days. -Eden and Isabella B
It was fun because I loved to code the robots - Cody
We played with robots and I made my robot dance with Addy's. We controlled them with an app. - Gwen M
When you first arrive you'll see the building - it's pretty big. Once inside you'll see many inventions, starting with 3D printers to a robot dog! Its a great place to do brainstorming and to learn new ideas. - Lucas S
🎉 Grade 5 Castlemaine Excursion 🎉
On the 27th of November, Grade 5 students made their way to Castlemaine for the day. Teachers and students explored the Castlemaine Art Museum looking at many interesting works of art which complimented the terrific work Grade 5/6 have been undertaking with Mr Pocock. Students visited the Boorp Boorp Boondyil exhibition which is an interactive exhibition that featured a range of stunning artworks and experiences, each designed to offer a unique and immersive insight into Djaara culture, Country and community.
Students finished off their excursion with a trip to the Castlemaine Botanical Gardens where students explored a variety of flora. This learning was complimented by investigating how the future climate is predicted to change and how caretakers plan to keep the beautiful botanicals gardens flourishing.
I really enjoyed looking at the artwork in the Art Gallery - Lane
We stopped at the park that was there and we had a job to look for certain trees. We found a cork tree. A balloon flew over to us, we decided to play with the balloon. - Steph
The 2 museums were fantastic! I loved looking at the cool paintings and this white wedding dress that was like 100 years old, so pretty! - Lucy J
I enjoyed being able to learn about the plants at the Botanical gardens and being able to walk around it with my friends. I enjoyed the scavenger hunt with the trees, it was fun identifying them. - Kaylee D
I liked the Art museum and all of the cool stuff and Boorp Boorp Boondyil exhibition, the taxidermy fox was interesting. - Savannah L
🎭 Production 🎭
The production is about a family of 4 who tell 2 different stories each , Nan, Pop, Grandson and Granddaughter, and are hosted by Toni Baa Baa Black Sheep. Nan tells the stories of Hansel and Gretel and Puss in Boots, Pop tells the story of Rumpelstiltskin and Jack And The Corporate Ladder, Grandson tells the story of the Three Little Pigs and Bunjil and Waa and lastly, but definitely not least granddaughter told Bunjil the Creator and Three Billy Goats Gruff, in the end Nan won the prize for the best story teller.
I thought the production was great, from the music, to the lines and to the placement. It’s like eating ‘little bit salted and a little bit sweetened popcorn’ it’s weird but yum, same as the production, it was weird but funny and fun to watch.
To be in the play (as an actor) my heart was beating 8 times the second of a normal heart. It felt like life or death, I was so scared. Happily, it turned out ok and people said I did greatbut I’d pay more respect to the singers and rappers for singing/rapping in front of quite a large audience. - Hudson Q
The costumes were so cool! But when I was narrating I had to wear this massive jacket and a small little hat. The jacket was so humungus we had to roll my sleeves up a lot. I really liked the costume for Three Billy Goats Gruff though. The hats were amazing!!! I loved the sparkles and glimmer. It made a nice big statement. The costumes were so good. With the Bunjil The Creator all of the people opening their jackets and revealing splashes of colour looked so good! - Lucy J
My favourite song was Bunjil and Waa because it was catchy and I liked the dance moves for the song. I liked watching other classes dance, so I can see how it's going to be like. -Hunter C
I really enjoyed the production because we came up with the dance moves and listening to all the songs in Story time showdown. My favourite song was Jack and The Corporate Leader. Also, the costumes were really cool. My favourite costume was Bunjil and Waa. I liked performing in front of all the people and it was really fun because it was my first time. Thank you to Mr Mayes, for creating the production. - Kobe
On production night I had so much fun, I have never performed in front of 8 hundred people before. I was nervous when I was on stage for the Hansel and Gretal but then it wasn't scary for the second song. But when the last song was over I had so much fun I wanted to go on again. -Ella W
🎾 Division Tennis 🎾
Girls: We left on the bus to go to the tennis center which was in the middle of the town. We finally arrived at the center and started to find our seats, and waited to be told to get ready for the first big game! We got ready and played, some of us won and some of us lost but there were some good games being played. The doubles were really fun because it was two versus two. We played for many hours while the sun was beating down on us, which was making us exhausted and thirsty. We made sure to keep hydrated and put our hats on while we played. We thank Miss Chamings and the parents for helping us during the day, we couldn’t have done this without you. Thank you for making this day possible!
Boys: The boys started off by getting to know the groups and then in the first round we had a bye, but the girls didn't, so we watched them play and they played pretty well but most of them lost and some didn't. But after that round, the boys group went to their spots and started the game some lost but most won. After our 1 verses 1, it is time to do our 2 verses 2. We played for hours and hours doing that exact rotation until we were finished and we sadly didn't win but it was fun anyways.
-Hannah and Eli F
🏏 Grade 5/6 Cricket 🏏
Epsom Primary School cricketers made their way to Catherine Macaulay College to take part in the annual Cricket tournament. The boys, coached by Mr Gilmore and the girls coached by cricketing extraordinaire Mr Jacobs had a fun and enjoyable day playing cricket against many different schools around Bendigo. Although either team weren't able to make it to the final, Epsom students represented the school proudly displaying acts of sportsmanship and comradery and ultimately experiencing what matters most, just having fun! Well done to all who participated.
It was really hot, and I enjoyed the win we had. We played with good sportsmanship.- Cooper B
I liked all the teams, they were really challenging and were good to play with. I enjoyed our win over St Monicas.- Denny G